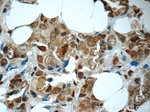
HuR Antibody in Immunohistochemistry (Paraffin) (IHC (P))

Search
Proteintech
HuR Polyclonal Antibody
{{$productOrderCtrl.translations['antibody.pdp.commerceCard.promotion.promotions']}}
{{$productOrderCtrl.translations['antibody.pdp.commerceCard.promotion.viewpromo']}}
{{$productOrderCtrl.translations['antibody.pdp.commerceCard.promotion.promocode']}}: {{promo.promoCode}} {{promo.promoTitle}} {{promo.promoDescription}}. {{$productOrderCtrl.translations['antibody.pdp.commerceCard.promotion.learnmore']}}
产品信息
11910-1-AP
种属反应
已发表种属
宿主/亚型
分类
类型
抗原
偶联物
形式
浓度
规格
纯化类型
保存液
内含物
保存条件
运输条件
产品详细信息
Immunogen sequence: MSNGYEDHM AEDCRGDIGR TNLIVNYLPQ NMTQDELRSL FSSIGEVESA KLIRDKVAGH SLGYGFVNYV TAKDAERAIN TLNGLRLQSK TIKVSYARPS SEVIKDANLY ISGLPRTMTQ KDVEDMFSRF GRIINSRVLV DQTTGLSRGV AFIRFDKRSE AEEAITSFNG HKPPGSSEPI TVKFAANPNQ NKNVALLSQL YHSPARRFGG PVHHQAQRFR FSPMGVDHMS GLSGVNVPGN ASSGWCIFIY NLGQDADEGI LWQMFGPFGA VTNVKVIRDF NTNKCKGFGF VTMTNYEEAA MAIASLNGYR LGDKILQVSF KTNKSHK (1-326 aa encoded by BC003376)
靶标信息
The protein encoded by this gene is a member of the ELAVL protein family. This encoded protein contains 3 RNA-binding domains and binds cis-acting AU-rich elements. It destabilizes mRNAs and thereby regulates gene expression.
仅用于科研。不用于诊断过程。未经明确授权不得转售。
生物信息学
蛋白别名: ELAV (embryonic lethal, abnormal vision, Drosophila)-like 1 (Hu antigen R); ELAV like 1; Elav-like generic protein; ELAV-like protein 1; embryonic lethal, abnormal vision, drosophila, homolog-like 1; Hu antigen R; HU-antigen A; Hu-antigen R; Human antigen R; HuR; MelG; unnamed protein product
基因别名: 2410055N02Rik; ELAV1; ELAVL1; Elra; Hua; HUR; MelG; W91709
UniProt ID: (Human) Q15717, (Mouse) P70372, (Rat) B5DF91
Entrez Gene ID: (Human) 1994, (Mouse) 15568, (Rat) 363854